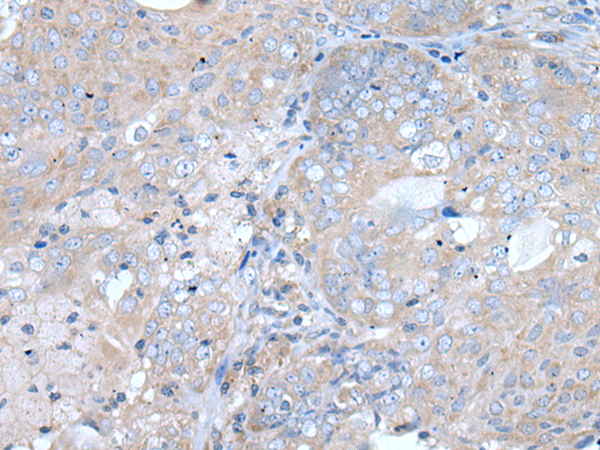

中文名稱: 兔抗TRPC5多克隆抗體
|
Background: |
This gene belongs to the transient receptor family. It encodes one of the seven mammalian TRPC (transient receptor potential channel) proteins. The encoded protein is a multi-pass membrane protein and is thought to form a receptor-activated non-selective calcium permeant cation channel. The protein is active alone or as a heteromultimeric assembly with TRPC1, TRPC3, and TRPC4. It also interacts with multiple proteins including calmodulin, CABP1, enkurin, Na(+)-H+ exchange regulatory factor (NHERF ), interferon-induced GTP-binding protein (MX1), ring finger protein 24 (RNF24), and SEC14 domain and spectrin repeat-containing protein 1 (SESTD1). |
|
Applications: |
ELISA, IHC |
|
Name of antibody: |
TRPC5 |
|
Immunogen: |
Synthetic peptide of human TRPC5 |
|
Full name: |
transient receptor potential cation channel, subfamily C, member 5 |
|
Synonyms: |
TRP5; PPP1R159 |
|
SwissProt: |
Q9UL62 |
|
ELISA Recommended dilution: |
5000-10000 |
|
IHC positive control: |
Human lung cancer and human prostate cancer |
|
IHC Recommend dilution: |
25-100 |

購物車
幫助
021-54845833/15800441009
